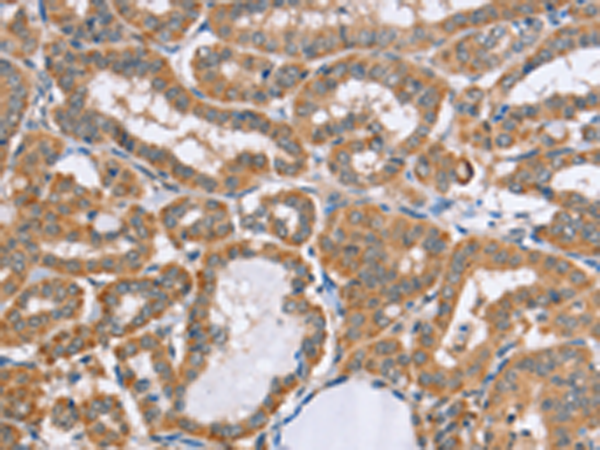
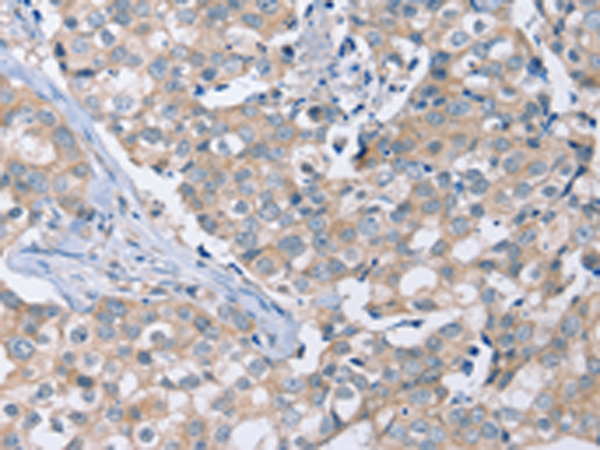

-
分类: 科研抗体货号: P08615别名: GSD10; PGAMM; PGAM-M应用: WB,IHC反应种属: Human, Mouse, Rat
-
分类: 科研抗体货号: P08598别名: PL; PTL; PNLIPD应用: WB,IHC反应种属: Human, Mouse
-
分类: 科研抗体货号: P08614别名: PFK-B; PFK-L; ATP-PFK应用: IHC反应种属: Human, Mouse, Rat
-
分类: 科研抗体货号: P08597别名: ADE2; AIRC; PAIS; ADE2H1应用: WB,IHC反应种属: Human, Mouse, Rat
-
分类: 科研抗体货号: P08613别名: MSP; PSP; IGBF; MSPB; PN44; PRPS; HPC13; PSP57; PSP94; PSP-94应用: WB,IHC反应种属: Human
-
分类: 科研抗体货号: P08595别名: CT16.4; GAGEC2; GAGEE2; PAGE-2应用: WB,IHC反应种属: Human
-
分类: 科研抗体货号: P08612别名: ABP32; PEF1A应用: WB,IHC反应种属: Human, Mouse, Rat
-
分类: 科研抗体货号: P08594别名: CT16; CT16.1; CT16.2; GAGEE1; PAGE-5应用: IHC反应种属: Human
-
分类: 科研抗体货号: P08611别名: PED; MAT1; HMAT1; MAT1H; PEA-15; HUMMAT1H应用: IHC反应种属: Human, Mouse, Rat
-
分类: 科研抗体货号: P08593别名: WIG1; WIG-1; PAG608应用: IHC反应种属: Human, Mouse, Rat

鄂公网安备42018502007531号
鄂公网安备42018502007531号

